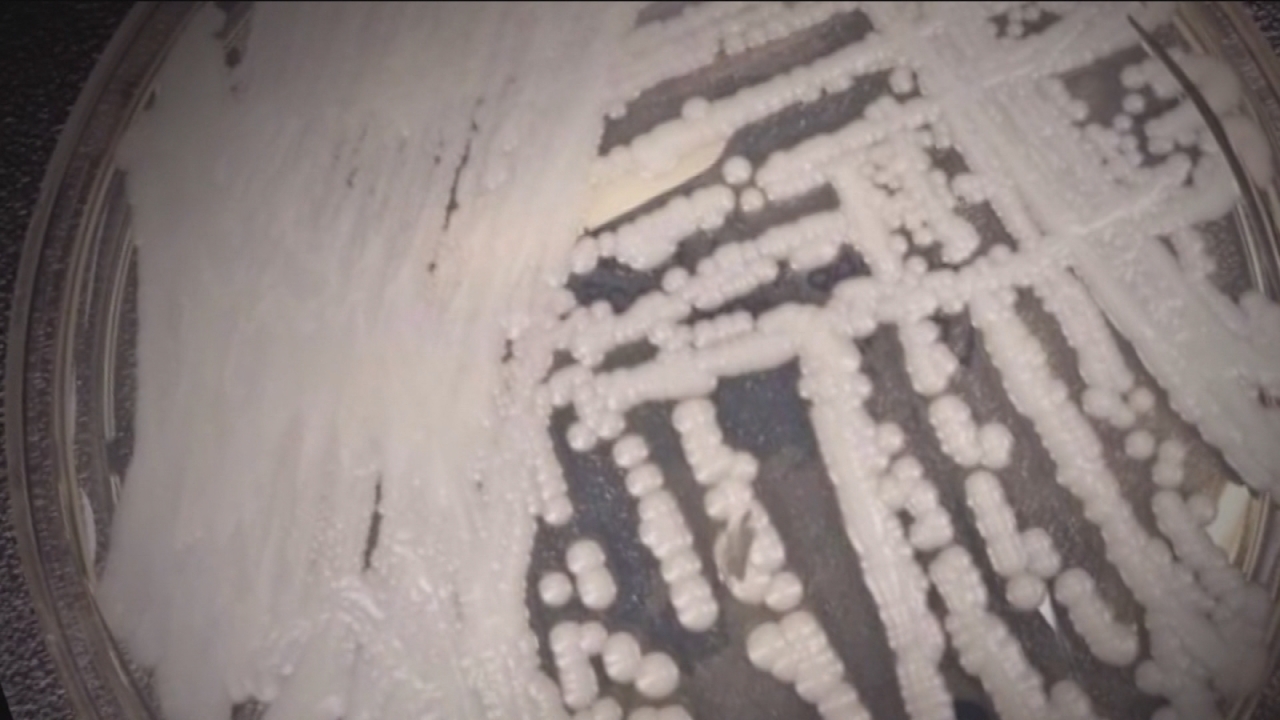

Un hongo que se ha convertido en una verdadera amenaza debido a sus particulares características: se propaga silenciosamente, es resistente a los medicamentos y en un 70% de los contagios, los pacientes han muerto.
"Da un poco de miedo. Alguien tiene que encontrar una solución de que hacer al respecto", asegura María Camacho, la hija de una paciente de un hospital en Brooklyn, EE.UU.
Hablamos del hongo Candida Auris, el que tiene en alerta a gran parte del mundo debido a lo difícil que es poder erradicarlo.
En el 90% de los casos la infección del hongo se ha mostrado resistente al menos a un fármaco, mientras que en el 30% lo han hecho con uno o dos medicamentos. Los expertos aseguran que esta característica se debe al uso excesivo de antibióticos.
Lee también: La extrema alergia de un niño que no puede comer, tocar ni estar en una habitación donde haya maní
Y es que los casos han aumentado de forma considerable este último tiempo en países como Gran Bretaña, India, Sudáfrica y Australia. Sólo en Estados Unidos se han confirmado más de 550 casos de este agente.

Es importante señalar que este hongo afecta principalmente a pacientes hospitalizados y con su sistema inmune debilitado, de ahí las alertas que existen en hospitales.
"Puede producir una infección de la sangre: la fungemia, puede producir infecciones de heridas operatorias, infecciones ópticas. Se ha asociado a la meningitis, a la endocarditis", entre otras enfermedades detalla la doctora Leonor Jofre, perteneciente a la Sociedad chilena de infectología. "El rango es bastante amplio", apunta.
Te puede interesar: Prometedora vacuna contra el cáncer logra curar el linfoma de 3 pacientesEn la misma línea, destaca que el hongo "tiene esta capacidad de persistir, por ejemplo: un paciente fallece, pero puede dejar contaminado todo su ambiente", clarifica.
Un agente infeccioso que va en aumento, de hecho en nuestra región ya se ha detectado en Colombia y Venezuela. Mientras que en Chile el primer aislamiento de Candida Auris fue realizado este verano en el Hospital El Salvador.